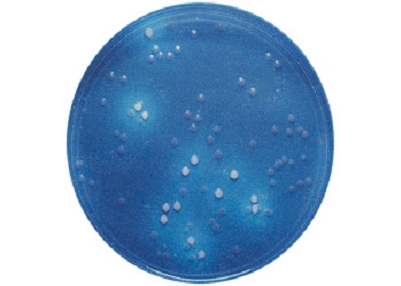

Mac CONKEY AGAR MUG es un medio fluorogénico para detección diferencial de E.coli (fluorescente) de los demás coliformes (no fluorescentes)
Enumeración de coliformes y diferenciación de E.coli en la primera siembra.
COMPOSICIÓN
Peptona de caseina 17,000 g
Peptona de carne 3,000 g
Cloruro sódico 5,000 g
Lactosa 10,000 g
Sales biliares 1,500 g
Rojo neutro 0,030 g
Cristal violeta 0,001 g
MUG 0,100 g
Agar agar 13,500 g
(Fórmula por litro)
pH final: 7,1 ± 0,2

Mac Conkey Agar MUG con E. coli fluorescente (curiosamente rosa en vez de azul) bajo luz U.V. 366 nm.
PREPARACIÓN
Disolver 50 g de medio en 1 litro de agua destilada.
Calentar agitando hasta ebullición Autoclavar a 121 ºC durante 15 minutos.
PARA USO EXCLUSIVO EN LABORATORIO.
AGITE EL BOTE ANTES DE USAR. MANTENGA EL BOTE BIEN CERRADO EN LUGAR SECO, FRESCO Y OSCURO.
PRECAUCIÓN: CONTIENE SALES BILIARES.
DESHIDRATADO CODIGO: DMT074
CONTROL DE CALIDAD DEL MEDIO
Realizado en nuestro laboratorio; es prudente repetirlo en su laboratorio siempre que varíen las condiciones (más de 3 meses sin usar, tras desinfectar laboratorio, tras conservar a alta Tª, cuando adquiere aspectos extraños aunque no haya llegado la fecha de caducidad teórica de la etiqueta,…)
DESHIDRATADO: Polvo grueso, púrpura. PREPARADO: Estéril, púrpura
CONTROL DE CRECIMIENTO 18-24 h a 37°C aproximadamente:
- Salmonella abony MKTN 6017, Colonia Incolora sin zona fluorescente.
- Bacillus subtilis MKTA 6633, Negativo.
- Pseudomonas aeruginosa MKTA 9027, Correcto, colonia incolora sin zona fluorescente.
- Escherichia coli MKTA 25922, Correcto, Colonia violeta oscuro con zona fluorescente.
- Klebsiella oxytoca MKTA 13182, Correcto, colonia violeta oscura sin zona fluorescente.
PRESENTACIÓN: TUBOS PREPARADOS 20 ml, FRASCOS PREPARADOS 100 ml, MEDIO DESHIDRATADO, DESINFECTEST-EC.
NOTA: El compuesto fluorogénico 4 Metil Umbeliferil Beta D Glucurónido (MUG), añadido al Mac Conkey Agar, permite la detección directa en placa de E. coli. La enzima Beta Glucuronidasa, presente en el 97% de las cepas de E.coli, hidroliza el MUG presente en el medio, liberando el compuesto 4 Umbeliferona, fuertemente fluorescente cuando se observa en la oscuridad bajo luz de 366 nm (Linterna MICROKIT). La mayoría de cepas enteropatogénicas de E.coli son Beta Glucuronidasa +. Miembros del género Citrobacter y del grupo KES (Klebsiella, Enterobacter, Serratia) pueden dar falsos positivos con MUG: Confirmar con la prueba del Indol, que sólo es positiva para E. coli.
SIEMBRA
Preparar placas fundiendo tubos o frascos y sembrar en estría o en masa. Incubar a 37 ºC aproximadamente, durante 18 24 horas. Si se prolonga la incubación no se distinguirán las colonias fluorescentes de las no fluorescentes.
INTERPRETACIÓN
Enterobacterias: Colonias incoloras. Coliformes: Colonias rojas. E. coli: Fluorescencia azul bajo luz U.V. 366 nm (linterna MICROKIT), en la oscuridad. Confirmar con la prueba del indol.
El usuario final es el único responsable de eliminar los microorganismos de acuerdo con la legislación medioambiental vigente. Autoclavar antes de desechar a la basura.
Si desea más información sobre nuestros MEDIO Mac CONKEY AGAR MUG , rellene nuestro formulario de contacto http://www.medioscultivo.com/contacto . O si lo prefiere póngase en contacto con nosotros a través de nuestro correo electrónico microkit@microkit.es o por teléfono en el nº 91-897 46 16
https://www.microkit.es/fichas/Mac-CONKEY-AGAR-MUG.pdf